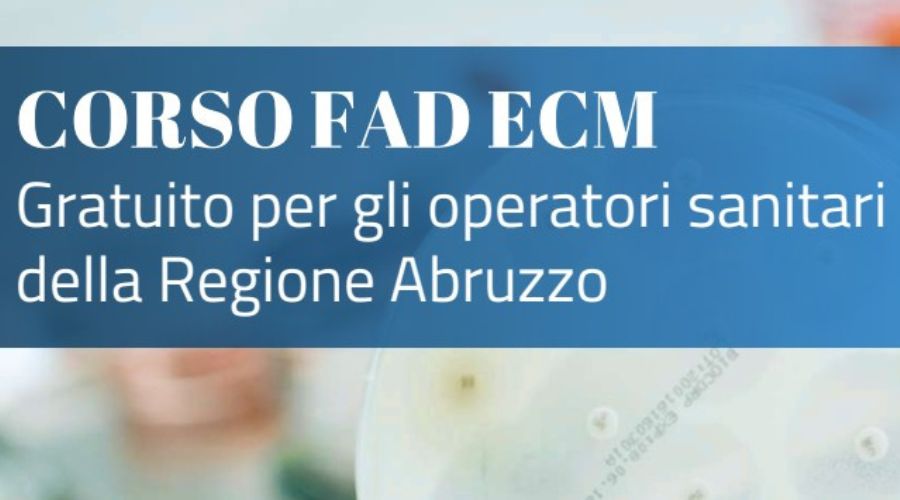

La Regione Abruzzo ha aderito al progetto nazionale AIFA COSIsiFA (Cittadini e Operatori Sanitari sempre INformati sul FArmaco) mediante il Servizio Farmaceutico Regionale, con il coordinamento del Centro Regionale di Farmacovigilanza.
Nell’ambito del progetto e tra i differenti Work Packages (WP), la Regione Abruzzo ha aderito anche al WP7 relativo alla Formazione sulle aree tematiche previste dal bando (cronicità e politerapia, antibiotico-resistenza, pediatria, oncologia).
Nel dettaglio, si comunica che sono attivi e disponibili gratuitamente in modalità asincrona i corsi FAD ECM sul tema della “Revisione della terapia e riduzione dei farmaci nell’anziano” (previsti 14 crediti ECM) ed il corso “Uso appropriato degli antibiotici (con approfondimenti EBM)” (previsti 12 crediti ECM). I corsi accreditati fino al 31.12.2026 sono accessibili e gratuiti per tutte le professioni sanitarie e operatori sanitari della Regione Abruzzo.
Per accedere è necessario registrarsi alla piattaforma mediante il link www.saepe.it, come indicato nelle locandine che si allegano alla presente. I corsi sono disponibili anche sul sito Crfv Abruzzo (https://www.crfv-abruzzo.it ) nella sezione “Corsi di formazione”. Per maggiori informazioni circa il progetto COSIsiFA vi invitiamo a consultare il sito www.InFarmaco.it.
Il Centro Regionale di Farmacovigilanza della Regione Abruzzo, in collaborazione con il DPF003, vi terrà informati sui futuri corsi che si renderanno disponibili.